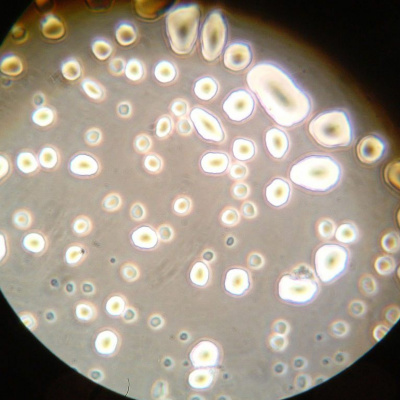
Val 202 - Soundcloud

Val 202 - Soundcloud
FX: Bakterije so lahko ključ do sreče in zdravja
- Autor: Vários
- Narrador: Vários
- Editor: Podcast
- Duración: 0:15:20
- Mas informaciones
Informações:
Sinopsis
Slovenski biologi so odkrili, da imajo bakterije vpliv na razmnoževanje pajkov. Kako vplivajo na vedenje drugih živali? Je lahko morda od bakterij celo odvisno vedenje ljudi?